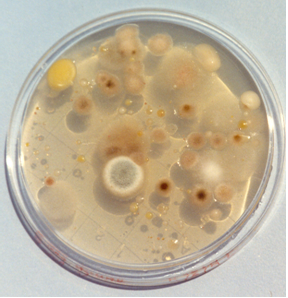
Nueva imagen

AGAR COMUN-NUTRIENT AGAR medio sólido para el recuento total de aerobios mesófilos según APHA en cosméticos y otros productos
Recuento total en productos cosméticos (APHA)
COMPOSICIÓN
- Extracto de carne 1,0 g
- Extracto de levadura 2,0 g
- Peptona 5,0 g
- Cloruro sódico 5,0 g
- Agar agar 12,0 g
(Fórmula por litro)
pH final: 7,4 ± 0,2
PREPARACIÓN
Disolver 25 g de medio en 1 litro de agua destilada.
Calentar agitando hasta ebullición para su completa disolución.
Repartir en tubos o frascos.
Autoclavar a 121 ºC durante 15 minutos.
PARA USO EXCLUSIVO EN LABORATORIO.
MANTENGA EL BOTE BIEN CERRADO
EN LUGAR SECO, FRESCO Y OSCURO.
AGITE EL BOTE ANTES DE USAR.
DESHIDRATADO CODIGO: DMT089
CONTROL DE CALIDAD DEL MEDIO
Realizado en nuestro laboratorio; es prudente repetirlo en su laboratorio siempre que varíen las condiciones (más de 3 meses sin usar, tras desinfectar laboratorio, tras conservar a alta Tª, cuando adquiere aspectos extraños aunque no haya llegado la fecha de caducidad teórica de la etiqueta,…)
DESHIDRATADO: Polvo grueso, Beige. PREPARADO: Estéril, Blanquecino.
CONTROL DE CRECIMIENTO CUANTITATIVO 24-48 h a 37°C aproximadamente, o bien 72 h a temperatura ambiente (21-28°C aproximadamente):
- Escherichia coli MKTA 25922, Excelente. Con respecto a PCA estandarizado*, recuento 95-178%
- Enterococcus faecalis MKTA 29212, Excelente. Con respecto a PCA estandarizado*, recuento 89-129%
- Staphylococcus aureus MKTA 6538P, Excelente. Con respecto a PCA estandarizado*, recuento 95-191%
- Pseudomonas aeruginosa MKTA 9027, Excelente. Con respecto a PCA estandarizado*, recuento 91-118%
* El que cumple con recuperación superior al 92-125% con respecto a cepas cuantitativas trazables a la cepa tipo. Incertidumbres detectadas entre todos los lotes a lo largo de un año (la mayoría de la incertidumbre se debe a la cepa y a la proporción de cepas acompañantes inoculadas, no al medio).
PRESENTACIÓN: TUBOS 20 ml con REACTIVO CROMOGÉNICO y Tiosulfato, FRASCOS 100 ml con REACTIVO CROMOGÉNICO y Tiosulfato, MEDIO DESHIDRATADO (sin REACTIVO CROMOGÉNICO ni Tiosulfato Sódico, que son opcionales).
Medio de cultivo básico utilizado para el cultivo de microorganismos no particularmente exigentes (APHA), es el más habitual en muestras de agua y en cosmética. Para aguas, mejor ver Yeast Extract Agar (s/ ISO 6222).
SIEMBRA E INTERPRETACIÓN
Fundir los tubos 20 ml o los frascos 100 ml para elaborar placas o para sembrar 1 ml de muestra en masa. Incubar a 37 ºC aproximadamente, durante 24-48 horas (flora patógena y asociada) y un duplicado a 22°C aproximadamente, durante 72 horas (flora saprófita) . Efectuar el recuento o el aislamiento. En el medio con REACTIVO CROMOGÉNICO, las colonias serán rojas y contrastarán con el fondo blanquecino, distinguiéndose de las partículas de la muestra. Puede añadirse este reactivo (SDA018) al medio deshidratado, cuando éste se ha enfriado a 47-50 ºC; en tal caso, no recalentar/refundir después.
El usuario es el único responsable de la eliminación de los microorganismos según la legislación medioambiental vigente. Autoclavar antes de desechar a la basura.
https://www.microkit.es/fichas/NUTRIENT-AGAR.pdf
Si desea más información sobre nuestros NUTRIENT AGAR (AGAR COMUN) rellene nuestro formulario de contacto http://www.medioscultivo.com/contacto . O si lo prefiere póngase en contacto con nosotros a través de nuestro correo electrónico microkit@microkit.es o por teléfono en el nº 91-897 46 16